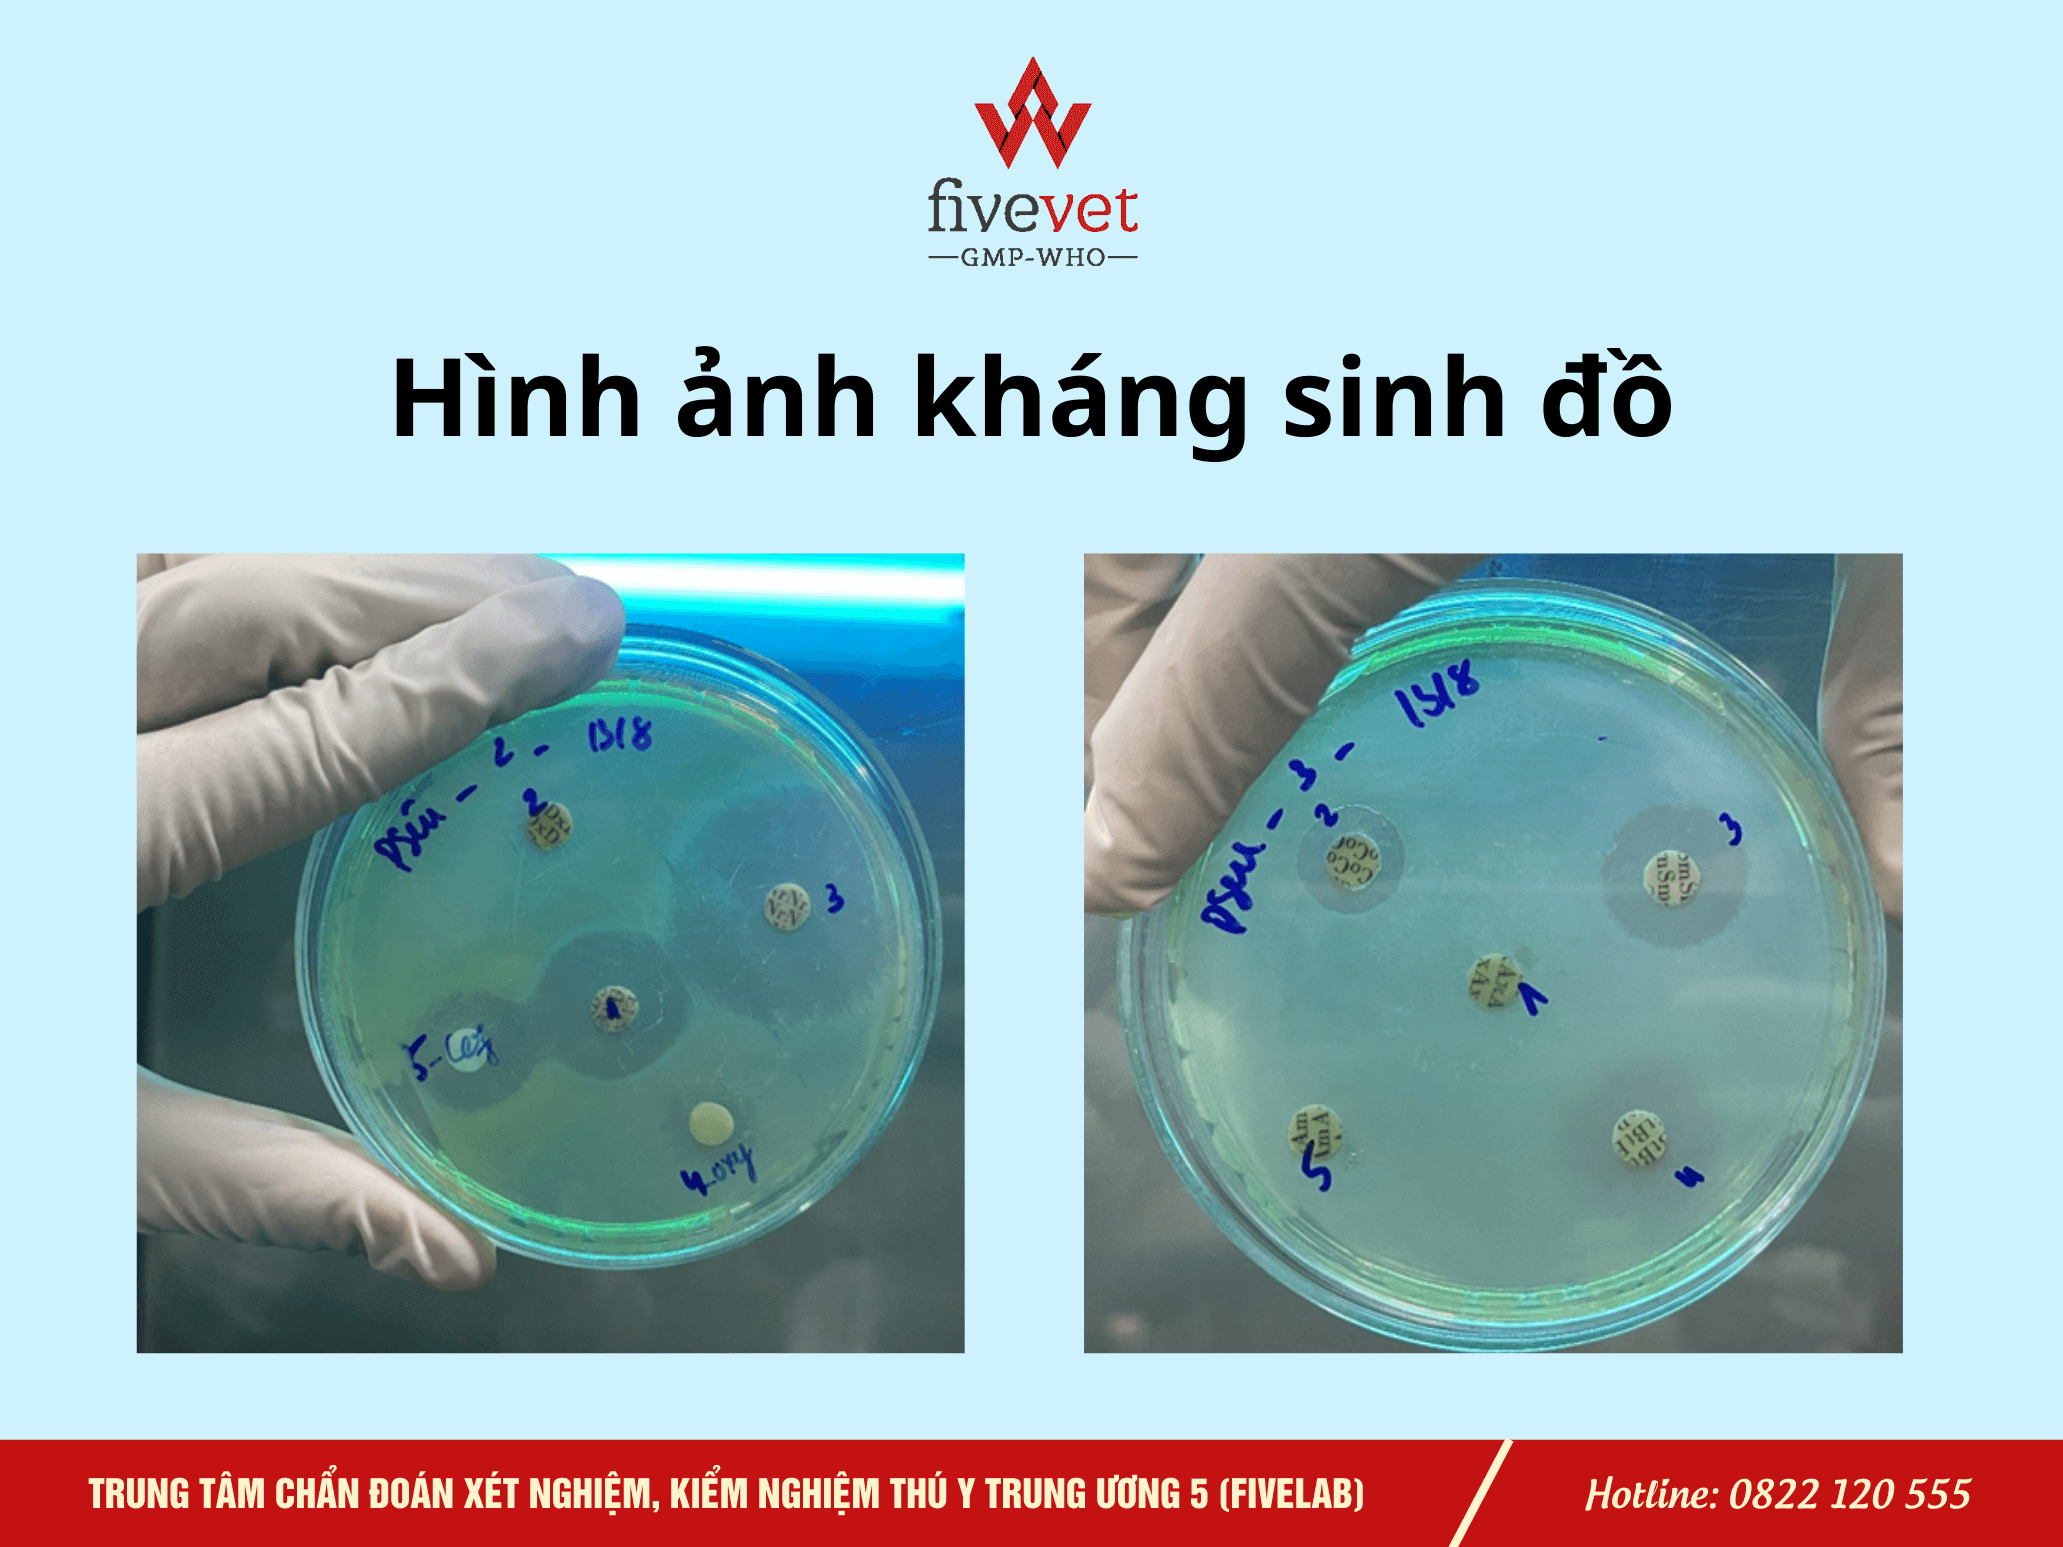

Kháng sinh đồ thú y (AST) là phương pháp quan trọng giúp lựa chọn kháng sinh phù hợp, nâng cao hiệu quả điều trị và giảm kháng kháng sinh. Bài viết này, Fivevet chia sẻ chi tiết nguyên lý, quy trình thực hiện, ưu nhược điểm và ứng dụng thực tiễn trong chẩn đoán, điều trị và quản lý sử dụng kháng sinh trong chăn nuôi.
Kháng sinh đồ thú y (AST)
1. Giới thiệu chung
Kháng sinh đồ (Antibiotic Susceptibility Testing – AST) là kỹ thuật vi sinh quan trọng nhằm xác định mức độ nhạy cảm hoặc đề kháng của vi khuẩn đối với các loại kháng sinh khác nhau. Trong bối cảnh tình trạng kháng kháng sinh ngày càng gia tăng ở cả y học người và thú y, việc lựa chọn kháng sinh dựa trên kết quả kháng sinh đồ đóng vai trò then chốt, giúp nâng cao hiệu quả điều trị, giảm thiểu thất bại điều trị và hạn chế sự lan rộng của vi khuẩn đa kháng thuốc.
Trong lĩnh vực thú y, kháng sinh đồ không chỉ hỗ trợ chẩn đoán và điều trị bệnh cho vật nuôi mà còn có ý nghĩa quan trọng trong kiểm soát dịch bệnh, quản lý sử dụng kháng sinh hợp lý, đảm bảo an toàn thực phẩm và bảo vệ sức khỏe cộng đồng. Kết quả kháng sinh đồ cung cấp cơ sở khoa học giúp bác sĩ thú y lựa chọn kháng sinh phù hợp, đúng liều và đúng thời gian, từ đó nâng cao hiệu quả điều trị và giảm nguy cơ tồn dư kháng sinh trong sản phẩm chăn nuôi.
2. Nguyên lý chung của kháng sinh đồ
Kháng sinh đồ dựa trên nguyên lý đánh giá khả năng ức chế sự phát triển của vi khuẩn bởi kháng sinh trong điều kiện nuôi cấy in vitro. Khi tiếp xúc với kháng sinh ở nồng độ xác định, vi khuẩn nhạy cảm sẽ bị ức chế hoặc tiêu diệt, trong khi vi khuẩn đề kháng vẫn tiếp tục phát triển.
Kết quả kháng sinh đồ thường được phân loại thành ba mức:
- Nhạy (S – Susceptible): Vi khuẩn bị ức chế ở nồng độ kháng sinh điều trị thông thường.
- Trung gian (I – Intermediate): Hiệu quả điều trị chỉ đạt được khi dùng liều cao hoặc tại vị trí nhiễm khuẩn đặc biệt.
- Đề kháng (R – Resistant): Vi khuẩn không bị ức chế ở nồng độ điều trị thông thường.
Việc phân loại này được thực hiện dựa trên các tiêu chuẩn quốc tế CLSI (Clinical and Laboratory Standards Institute) hoặc EUCAST (European Committee on Antimicrobial Susceptibility Testing).
3. Kỹ thuật làm kháng sinh đồ bằng phương pháp khuếch tán trên thạch (kirby–bauer)
Đây là phương pháp kháng sinh đồ được sử dụng phổ biến nhất, dựa trên khả năng khuếch tán của kháng sinh từ đĩa giấy vào môi trường thạch đã cấy vi khuẩn.
3.1. Quy trình thực hiện chi tiết
Bước 1: Chuẩn bị huyền dịch vi khuẩn
- Sử dụng chủng vi khuẩn thuần, vừa nuôi cấy qua đêm.
- Pha huyền dịch trong nước muối sinh lý hoặc canh thang sao cho độ đục tương đương chuẩn McFarland 0,5 (≈10⁸ vi khuẩn/ml).
Bước 2: Ria vi khuẩn lên đĩa thạch
- Thực hiện trong vòng 15 phút sau khi pha huyền dịch.
- Dùng 100µl canh khuẩn nhỏ lên đĩa thạch Mueller-Hinton.
- Dàn đều bằng que trang và để khô mặt thạch 3-5 phút (không quá 15 phút).
Bước 3: Đặt khoanh giấy kháng sinh
- Lựa chọn kháng sinh phù hợp dựa trên phổ tác dụng của vi khuẩn và hướng dẫn CLSI.
- Mỗi đĩa thạch đường kính 90mm đặt tối đa 7 khoanh giấy, khoảng cách giữa các khoanh ≥20mm và cách thành đĩa ≥15mm.
Lưu ý: Không di chuyển khoanh giấy sau khi đã đặt lên mặt thạch.
Bước 4: Ủ ấm và đọc kết quả
- Lật úp đĩa thạch, ủ ở 35-37°C trong 18-20 giờ.
- Đo đường kính vòng vô khuẩn (mm) và đối chiếu bảng chuẩn CLSI để phân loại S, I hoặc R.
Hình ảnh kháng sinh đồ
3.2. Đánh giá chất lượng và kiểm soát sai số
- Thực hiện kháng sinh đồ song song với chủng mẫu ATCC nhằm kiểm chứng độ chính xác của quy trình và điều kiện thử nghiệm.
- Kết quả kháng sinh đồ chỉ được chấp nhận khi đường kính vòng vô khuẩn của chủng ATCC nằm trong giới hạn cho phép theo tiêu chuẩn CLSI/EUCAST.
4. Các yếu tố ảnh hưởng đến độ chính xác
Độ chính xác của phương pháp kháng sinh đồ phụ thuộc chặt chẽ vào việc chuẩn hóa quy trình thực hiện. Một số yếu tố ảnh hưởng chính bao gồm:
Các yếu tố ảnh hưởng đến độ chính xác
Việc không kiểm soát tốt các yếu tố trên là nguyên nhân chính dẫn đến sai lệch kết quả kháng sinh đồ
5. Ưu điểm và hạn chế của phương pháp
5.1. Ưu điểm
- Quy trình đơn giản, dễ triển khai tại các phòng thí nghiệm quy mô nhỏ.
- Chi phí thấp hơn so với các hệ thống tự động hoặc phương pháp xác định MIC
- Tính chuẩn hóa quốc tế cao, dễ so sánh kết quả giữa các đơn vị.
5.2. Hạn chế
- Chỉ cung cấp kết quả định tính (S/I/R), không xác định được nồng độ ức chế tối thiểu (MIC).
- Không phù hợp cho vi khuẩn kỵ khí hoặc vi khuẩn mọc chậm.
- Khó phát hiện các cơ chế kháng kháng sinh phức tạp (như ESBL, Carbapenemase) nếu không thực hiện các thử nghiệm bổ sung.
6. Thời điểm thực hiện kháng sinh đồ thích hợp
Việc lựa chọn thời điểm lấy mẫu có ý nghĩa quyết định đến giá trị lâm sàng của xét nghiệm kháng sinh đồ:
- Trước khi bắt đầu điều trị: Là thời điểm lý tưởng nhất, vì vi khuẩn phản ánh đúng mức độ nhạy cảm tự nhiên, chưa chịu áp lực của kháng sinh.
- Khi điều trị thất bại: Chỉ định khi bệnh không đáp ứng với phác đồ ban đầu, bệnh tái phát nhiều lần hoặc nghi ngờ nhiễm vi khuẩn đa kháng.
- Trong công tác giám sát: Thực hiện định kỳ nhằm đánh giá tình hình dịch tễ học và hiệu quả các chính sách sử dụng kháng sinh trong chăn nuôi.
Lưu ý quan trọng: Mẫu bệnh phẩm cần được lấy trước khi sử dụng kháng sinh hoặc sau khi đã ngừng thuốc đủ 72h, nhằm đảm bảo vi khuẩn có khả năng sinh trưởng bình thường trong điều kiện nuôi cấy và cho kết quả kháng sinh đồ chính xác.
7. Kết luận
Kháng sinh đồ là công cụ không thể thiếu trong chẩn đoán và điều trị các bệnh nhiễm khuẩn. Việc lựa chọn đúng kỹ thuật và thực hiện xét nghiệm vào thời điểm thích hợp giúp nâng cao hiệu quả điều trị và hạn chế sự hình thành vi khuẩn kháng kháng sinh.
Trong bối cảnh kháng kháng sinh đang trở thành thách thức toàn cầu, việc tăng cường ứng dụng kháng sinh đồ trong thực hành thú y không chỉ góp phần bảo vệ sức khỏe vật nuôi mà còn đóng vai trò quan trọng trong đảm bảo an toàn thực phẩm và sức khỏe cộng đồng. Đây là yêu cầu cấp thiết và mang tính lâu dài đối với ngành thú y hiện đại.
Câu hỏi thường gặp:
1. Kháng sinh đồ thú y là gì?
Kháng sinh đồ thú y là kỹ thuật vi sinh nhằm xác định mức độ nhạy cảm hoặc đề kháng của vi khuẩn đối với các loại kháng sinh, giúp bác sĩ thú y lựa chọn phác đồ điều trị phù hợp và hiệu quả.
2. Khi nào nên thực hiện kháng sinh đồ?
Nên thực hiện trước khi điều trị kháng sinh, khi điều trị không hiệu quả, bệnh tái phát nhiều lần hoặc trong các chương trình giám sát kháng kháng sinh tại trang trại.
3. Kháng sinh đồ có giúp giảm kháng kháng sinh không?
Có. Việc lựa chọn kháng sinh dựa trên kháng sinh đồ giúp dùng thuốc đúng, đủ và hợp lý, từ đó hạn chế sự hình thành và lan rộng của vi khuẩn đa kháng.
4. Kháng sinh đồ có vai trò gì trong an toàn thực phẩm?
Kháng sinh đồ giúp hạn chế sử dụng kháng sinh không cần thiết, giảm nguy cơ tồn dư kháng sinh trong sản phẩm chăn nuôi và bảo vệ sức khỏe cộng đồng.
5. Kháng sinh đồ có xác định được liều dùng kháng sinh không?
Không. Phương pháp khuếch tán đĩa giấy chỉ cho kết quả định tính (S/I/R). Để xác định nồng độ ức chế tối thiểu (MIC), cần sử dụng các phương pháp chuyên biệt khác.
Xem thêm:
- Phương pháp phát hiện vi khuẩn gây bênh Glasser
- Phương pháp phát hiện và kiểm soát bệnh APP trên lợn
- Kỹ thuật phân lập và kháng sinh đồ vi khuẩn E. coli trên gia cầm